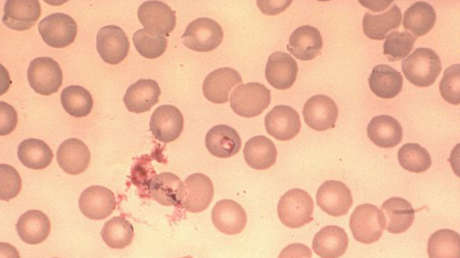
Enfermedad provocada por garrapatas se está propagando en algunos estados de EE.UU.

Una mujer de la ciudad malasia de Malaca llevó a su hija al hospital porque le dolía el oído y el médico encontró cientos de garrapatas dentro, informan medios locales citando una historia publicada por la propia madre de la niña en sus redes sociales.
La pequeña Hayfa se quejaba de dolor en el oído, pero su madre, Aqila Nasir, no encontró nada anormal al alumbrarle la cavidad auditiva con una linterna, por lo que no vio necesario llevarla al médico en ese momento. Al día siguiente, la niña estaba aletargada y se quejaba de dolor no ya solo en el oído, sino también en el cuello, por lo que Aqila de nuevo se lo examinó. En esa ocasión vio unos puntos negros, y entonces sí llevó la niña al doctor.
Cuando una especialista examinó a Hayfa, observó que dentro del oído había un centenar de garrapatas. La doctora utilizó una cámara para mostrarle a la paciente y a su madre multitud de pequeños puntos negros esparcidos por todo el canal auditivo. A la niña le limpiaron la oreja, eliminando poco a poco todas las garrapatas. Quitar insectos de dentro del oído es un proceso doloroso, pero la niña lo toleró con normalidad.
Según la madre, a Hayfa le dijeron que tomara analgésicos y la enviaron a casa. Tras el incidente, ocurrido la semana pasada, Aqila instó a las madres a escuchar siempre a sus hijos si dicen que no se encuentran bien. Sin embargo, señaló que sigue sin entender cómo pudieron entrarle garrapatas al oído, ya que la niña siempre lleva hiyab cuando juega al aire libre. Al mismo tiempo, indicó que la médica le preguntó si tenían gatos en casa, suponiendo al parecer que los insectos podían proceder de ellos.